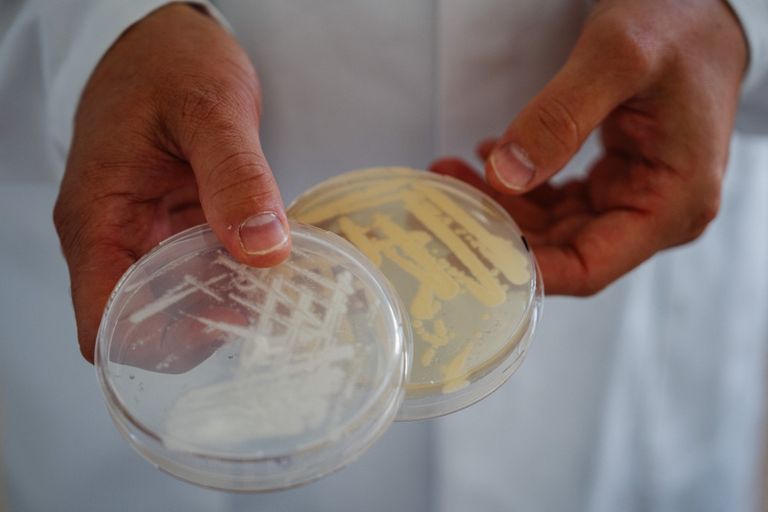
إنتاج بروتينات حليب أو بيض من دون استخدام الحيوانات

غذاء أخضر وانبعاثات أقل.. منتجات من البروتين دون حيوانات
تسعى شركات ناشئة إلى إنتاج بروتينات حليب أو بيض من دون استخدام الحيوانات.
وذلك عبر عملية تخمير موجّهة يتوصّلون من خلالها إلى منتج يحافظ على ملمس وطعم الأجبان أو البيض، لكن من دون البصمة الكربونية الخاصة بتربية المواشي.
داخل مختبرات "ستانديغ أوفايشن" في باريس، يبدأ تصنيع المنتج داخل غرفة مظلمة، إذ ينبغي إدخال إلى كائنات دقيقة (خميرة وفطريات وبكتيريا) جينات بقرة قادرة على إنتاج الكازيين، وهو البروتين الرئيسي الموجود في الحليب.

ثم "تنمو" كائنات دقيقة داخل قوارير قبل نقلها إلى أجهزة تخمير حيث تتكاثر عند خلطها بالماء والملح والنيتروجين والسكر. ومن قارورة بسعة 30 ملليلتراً، يمكن للشركة إنتاج لتر واحد خلال 24 ساعة.
ثم يخضع المنتج لعملية ترشيح ثم فصل للجزيئات بحسب كثافتها ثم تجريده من الكائنات الدقيقة المعدّلة وراثياً، حتى يصبح عبارة عن مسحوق أبيض تعتزم الشركة الناشئة توفيره للمصنّعين داخل أكياس تزن 25 كيلوغراماً. وتتولّى هذه المصانع تحويله إلى ما يعادل جبن الكممبير أو الكروتين أو الجبنة القابلة للدهن أو الآيس كريم.

وتكون هذه المنتجات مشابهة لنظيراتها من أصل حيواني أكثر من البدائل النباتية المصنوعة من زيت جوز الهند أو الكاجو مثلاً، على ما يؤكد المؤسس المشارك لـ"ستانديغ أوفايشن" رومان شايو.
ويقول "في النهاية، يكون البروتين المُنتج نفسه كالذي توفره البقرة".
إلا أنّ هذا المُنتج ليس حلاً معجزة بالنسبة إلى مَن يعانون حساسية من بروتينات الحليب، لكنه قد يكون جيداً لأولئك الذين لديهم حساسية على اللاكتوز، وهو السكر الموجود في الحليب.
ويمكن لـ"ستانديغ أوفايشن" أن تستند أيضاً إلى الحمض النووي الخاص بالماعز أو الخواريف أو الجواميس أو حتى الحيتان.
انبعاثات أقل
يُعدّ التخمير الذي يُستخدم في تحويل القمح إلى خبز مثلاً، طريقة مُثبتة منذ قرون في مجال تصنيع الأغذية.
لكن تمت في الآونة الأخيرة إضافة تقنيات تتيح تدريب كائنات دقيقة على إنتاج بروتينات أو انزيمات معينة.

وتشمل الاستخدامات الرئيسية لذلك إعادة إنتاج بروتينات الحليب (الكازيين ومصل اللبن)، أو البيض، أو مواد مثل الهيم الذي يستخدمه مصنعو البرغر النباتي لجعل منتجاتهم مشابهة للحوم الحمراء.
وعلى عكس اللحوم المُصنّعة من زرع الخلايا، لا تُستخدم الخلايا الحيوانية في عملية التخمير الموجّهة.
وانطلق القطاع عام 2020، مستقطباً استثمارات بقيمة 938 مليون دولار في العام 2021 و382 مليون دولار سنة 2022، بحسب "غود فود انستيتيوت" التي تشكل منظمة أميركية تروّج لبدائل اللحوم.
وأعلنت شركة "بون فيفان" الناشئة في ليون والتي تنتج أيضاً بروتينات من الحليب، أنها جمعت 15 مليون يورو إضافية لتستخدمها في تطوير أعمالها.
ودخل عدد من الشركات الأخرى هذا المجال في بلدان مختلفة كما في الولايات المتحدة (بيرفكت داي وإيفري) وألمانيا (فورمو) وإسرائيل (ري ميلك). وأشارت "غود فود انستيتيوت" إلى وجود 62 شركة مماثلة بمختلف أنحاء العالم في نهاية 2020.
وتُباع في الولايات المتحدة منذ العام 2020 منتجات من البوظة مصنوعة من بروتين مصل اللبن تنتجها شركة "برفكت داي".
وتأمل "ستانديغ أوفايشن" أن تتمكّن من طرح منتجها في الأسواق الأميركية اعتباراً من عام 2024، بحسب رومان شايو.
وتُعد إجراءات الحصول على ترخيص لـ"الأطعمة الجديدة" في دول الاتحاد الأوروبي أطول منها في الولايات المتحدة. وتسعى "ستانديغ أوفايشن" للحصول على ترخيص بين 2025 و 2026.
وتستخدم الشركة الناشئة راهناً جهاز تخمير هو عبارة عن خزان فولاذي تبلغ سعته 10 أمتار مكعبة، لكنها تطمح للانتقال على المدى البعيد إلى جهاز بسعة 200 متر مكعب. وتأمل أن تُطرح المنتجات المصنّعة من مسحوقها بنفس سعر نظيراتها الحيوانية.
وتُشجّع الجهات المُصنّعة هذه الابتكارات
وعقدت "ستانديغ أوفايشن" شراكة عام 2022 مع شركة "بيل" المصنعة لمنتجات "كيري" وبورسان" والتي بدأت تطرح في الأسواق منتجات جبنة نباتية.
وتجري كل من "نستله" و"يونيليفر" تجاربهما الخاصة في هذا المجال.
وتشير ستيلا تشايلد التي تعمل لدى "غود فود إنستيتيوت" لتعزيز الأبحاث في هذا المجال بأوروبا، إلى أن المنتجات الناتجة من التخمير الموجّه "تتسبب بانبعاثات أقل مما ينجم عن تربية المواشي"، التي يُعزى لها باستمرار تسببها بانبعاث غاز الميثان الناتج عن تجشؤ الحيوانات، كما أنها "تستخدم كميات أقل من المياه".
وتقول "على الحكومات مساعدة قطاع التخمير على التوسّع كما ساعدت في تطوير الطاقات المتجددة"، وذلك لدعم الصناعات الغذائية الأكثر استدامة.